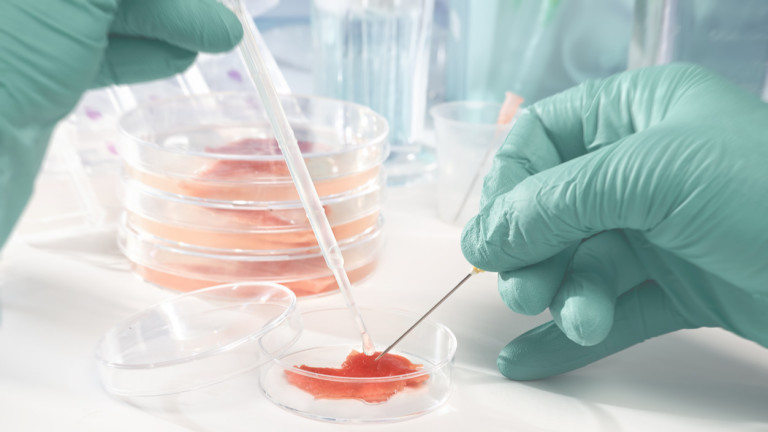

Никой не може да предскаже бъдещето, но е от значение да сте в час с промените в бизнес света, за да бъдете успешни. Повечето предприемачи винаги се опитват да изпъкнат пред тълпата като се опитват да хванат вълната на това, което става актуално през следващите десетилетия. И някои успяват. Други се отказват през първата си година, отчасти защото не са намерили правилната ниша за развитие.
През последните години сме свидетели на огромен технологичен напредък и светът е напълно преобразен, което означава, че трябва постоянно да се оглеждаме за нови бизнес възможности.
Да бъдеш собственик на бизнес или да си предприемач означава да поемеш риск, а никой не иска да поема рискове, които нямат смисъл.
Сайтът Webmarketing123 и Business Insider ни представят няколко бизнес тенденциите за бъдещето, които се очаква да бъдат високо доходоносни след десетилетие.
Източник: iStock
1. Отглеждане на месо в лаборатория
Както знаем, темата за устойчивата енергия и ефективното използване на ресурси е много актуална. Ресурсите продължават да намаляват от година на година и трябва да се промени нещо, за да се отговори на нуждите на нарастващото население в света. Животновъдството става все по-голяма пречка за околната среда, защото са нужни тонове храна и вода като същевременно са и източник на огромни количества замърсяване и отпадъци. Затова учените са разработили решение, което включва производството на месо, отглеждано в лаборатории.
Както и да гледате на тази концепция, тя би могла да бъде начинът, по който си набавяме месо в бъдеще. Той вероятно ще бъде подкрепен от защитниците на правата на животните и техните любители по целия свят, както и от хората, които се грижат за екологичното бъдеще на Земята.

Източник: iStock
2. Брачно консултиране
Разводите стават все по-често срещани, което естествено не е добра новина, но е възможност за развитието на успешен бизнес.
Статистическите данни показват, че необходимостта от брачни консултанти ще нарасне с около 41% до 2020 г. Цифрите ни говорят и за това как би могло да изглежда търсенето им след десетилетие. Стартирането на бизнес в тази област ще изисква да се позиционирате добре в бранша и да наемете специалисти по психично здраве, което би могло да ви донесе огромни печалби през следващите 10 години.

Източник: iStock
3. Вертикално земеделие
Още една възможност за справяне с недостига на храна на фона на растящото световно население. Идеята за т.нар. вертикално земеделие може да помогне в това отношение. Новият метод ще направи фермерството по-ефективно и продуктивно за единица площ. Също така се нуждае и от по-малко количество вода. Много градове вече инвестират в тази технология. Тя им помага да се сдобиват с храна в града, вместо да я набавят от ферми в близост до него. Това може да стане единственият начин за отглеждане на растения в бъдеще, така че възможността да ви донесе голяма печалба, е сериозна.

Източник: iStock
4. Управление на водните ресурси
Важно е да се мисли за бизнес идеи, които допринасят за един по-добър живот. Чистата вода очевидно е жизненоважна за обществото и неща като доставянето ѝ до домовете и предприятията има изключително значение. Бъдещите войни и конфликти вероятно ще се водят за ресурси като вода, а не петрол. Недостигът ѝ става все по-често срещана тема, което я прави потенциално важно и доходоносно бизнес начинание.

Източник: iStock
5. Слънчевата енергия
През последните няколко години светът все по-активно усвоява технологии за преобразуване на слънчевата светлина в топлинна и електрическа енергия. Експериментите в тази област стартират още преди 30 години, но пикът на строителство на слънчеви електроцентрали се случва през последното десетилетие. Дори вече някои правителства предлагат данъчни облекчения за компании, занимаващи се с това. В някои страни има и данъчни облекчения за собствениците на жилища, които решат да направят тази инвестиция. Може да се съсредоточите върху жилищната или търговката им страна като броят на хората и собствениците на бизнес, желаещи да инвестират в слънчева енергия, продължава да нараства.

Източник: iStock
6. Каравана за бързо хранене
Бизнесът на колела се превръща в привлекателна идея за предприемачите в развитите страни. Той се оказва изключително конкурентоспособен поради ниските разходи за стартирането и поддържането му и заради сравнително ниската такса за упражняване на дейността спрямо тази за стационарните магазини и заведения. Друга голяма привилегия е мобилността на този бизнес и това, че ако избрана от вас локация не е достатъчно доходоносна, тя лесно може да бъде сменена. Този тип бизнес е силно развит в САЩ, но предстои и разрастване на европейския пазар. Ако си изкарате необходимите разрешителни, изберете подходящо място, откриете надеждни доставчици и не на последно място, предлагате наистина добра храна, едва ли ще се провалите.

Източник: iStock
7. Микромобилност
Демографските промени и общият прираст на населението носят много промени в градовете. Все повече хора се местят да живеят там и пътуването става все по-затруднено. Тук идва и терминът микромобилност, който се ползва за решенията, свързани с придвижването на кратки разстояния в града. Това най-често са превозните средства, използвани за личен транспорт, като електрическата версия на велосипеди, скутери или скейтбордове, пише Business Insider. Микромобилността ще играе все по-ключова роля в решаването на някои от предизвикателствата в градовете, свързани с опазване на околната среда и спестяване на време. Ако градът или регионът, в който живеете, все още не предлага услугата за споделяне на превозни средства, това може да се окаже много добро бизнес решение. Съчетавайки го с убедително онлайн присъствие на компанията може и да монополизирате пазара.

Източник: Electromobility.com
8. Центрове за зареждане на електрически автомобили
Много от производителите като Tesla, Nissan, Toyota са се насочили към пазара на електрически автомобили. Не е и невъзможно в даден момент всички коли да станат електрически. Популярността на тези превозните средства расте, но липсват места, където да бъдат зареждани.
Вероятно ще отнеме време, докато бензиностанциите бъдат преобразувани в електрически станции или им бъде добавена такава опция. Затова помислете за възможността да стартирате с няколко малки станции за зареждане и един ден да превърнете малкия си бизнес във франчайзинг.

Източник: flickr.com
9. 3D принтиране
В началото 3D принтерите бяха доста скъпи и не особено предпочитани от предприемачите. Но с течение на времето цената им падна, макар че все още не са напълно достъпни за всеки. В момента цената им варира от около 2000 до 15000 долара като зависи от спецификациите и опциите, които искате. Възможността за директно производство на крайни продукти значително опростява работата на дизайнерите, чиито чертежи се пренасят директно от компютъра към 3D принтера. Така могат да се утвърдят нови бизнеси, които предлагат високоперсонализирани или съвместно проектирани продукти между човек и машина.
Oт Bugatti до Adidas 3D печатът вече има сериозно влияние в индустриите със своята технология, засягаща както процеса на производство, така и този на проектиране. Пазарният му дял се очаква да нараства с близо 23,5% всяка година през следващите пет, така че може би е идеалният момент да навлезете в този тип бизнес.

Източник: iStock
10. Персонализирано хранене
Хилядите препоръки за диети идват и си отиват като често объркват потребителите, вместо да им помагат, пише Business Insider. Персонализираното хранене обаче е насочено отделно към всеки потребител. Проучване сочи, че 15 милиона души са преминали генетични тестове под една или друга форма, което прави здравните данни по-изчерпателни от всякога. Известно е, че този тип хранене предотвратява (или понижава риска от получаване) на десетки болести, от сърдечни заболявания до диабет. Естествено, за да стартирате бизнес в тази посока ще ви е необходима квалификация в областта на храненето, човешката биология, физиология или поведенческа психология.